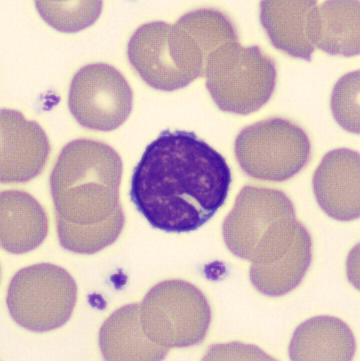
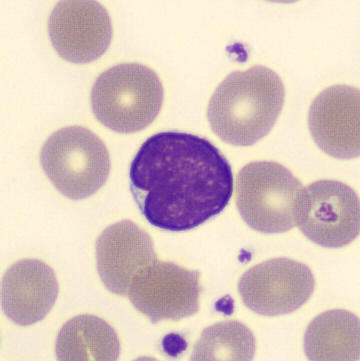
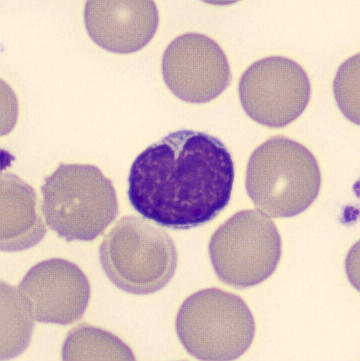
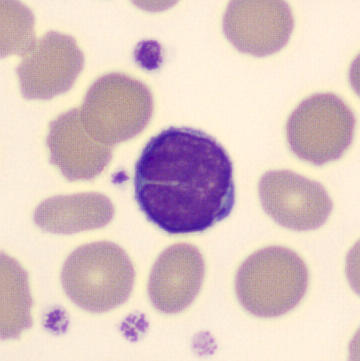
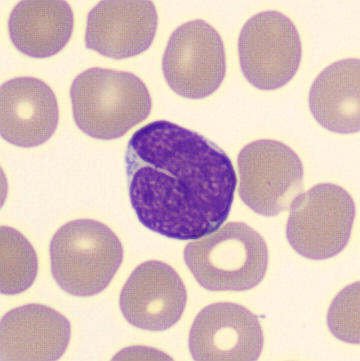
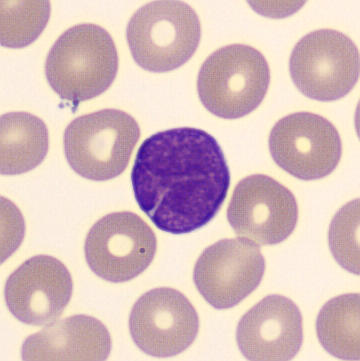
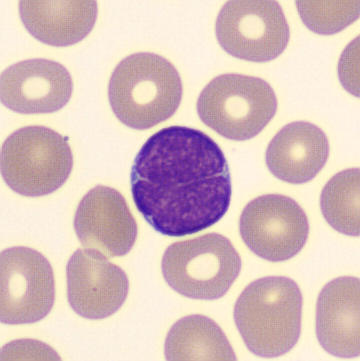
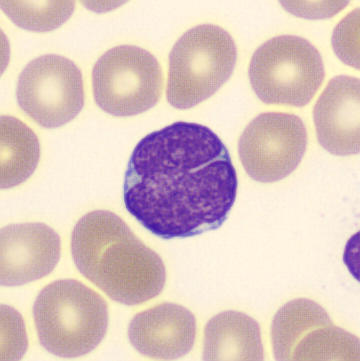
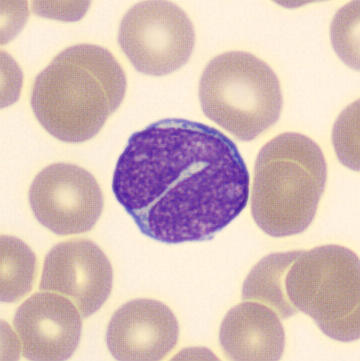
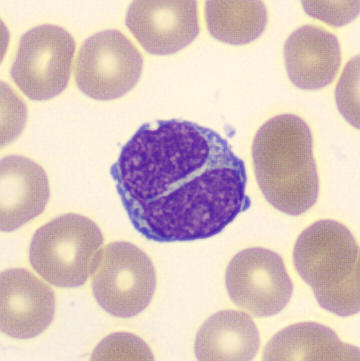
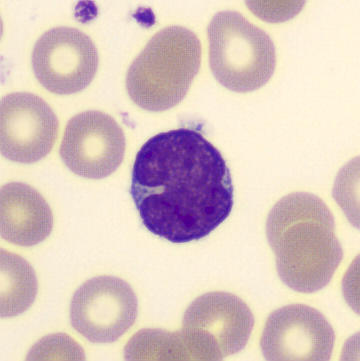
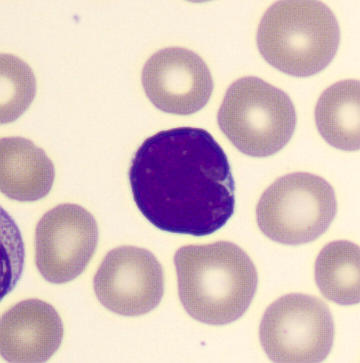

Cleft nucleus
Lymphocytes with a cleaved nucleus can be either benign or malignant in nature. In young children, it is a typical manifestation of infection with Bordetella pertussis (whooping cough). A large proportion of lymphocytes then exhibit this cleft.
In adults, lymphocytes with cleaved nuclei are more likely to be associated with lymphomas, such as follicular lymphoma and mantle cell lymphoma, or with atypical chronic lymphatic leukemia. The number of malignant lymphocytes exhibiting this abnormality can vary widely and may also be completely absent. See the syndromes section for some examples.
Whooping cough

Follicular lymphoma

Mantle cell lymphoma